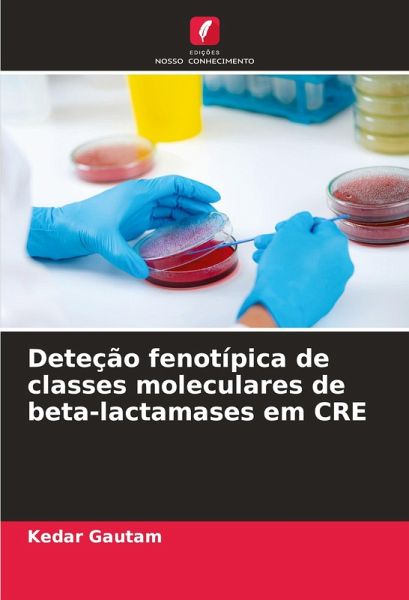

Deteção fenotípica de classes moleculares de beta-lactamases em CRE
Versandkostenfrei!
Versandfertig in 6-10 Tagen
39,99 €
inkl. MwSt.
PAYBACK Punkte
20 °P sammeln!
Este livro é um trabalho realizado no Kanti Children Hospital, em Katmandu, para determinar o peso dos isolados de Enterobacteriaceae resistentes aos carbapenemes que produzem diferentes tipos de ß-lactamases. Uma vez que se verifica uma grande variação nas ß-lactamases de CRE, para reduzir o risco de calamidade grave, são obrigatórios procedimentos de deteção eficazes em todos os laboratórios clínicos.